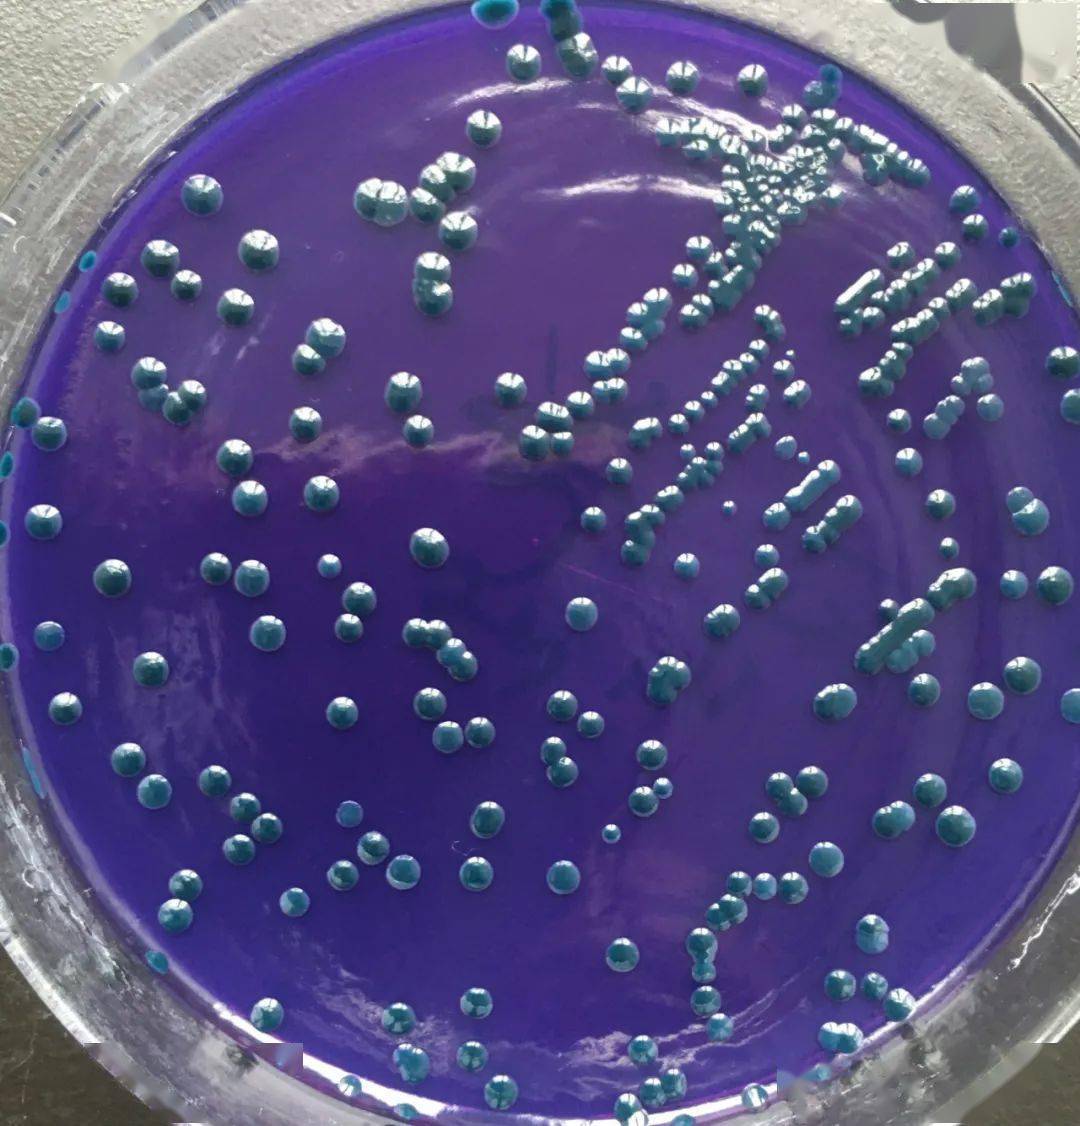
图5,绿弧菌菌落图6,枯草芽孢杆菌染色微生态制剂用于改善养殖水体环境
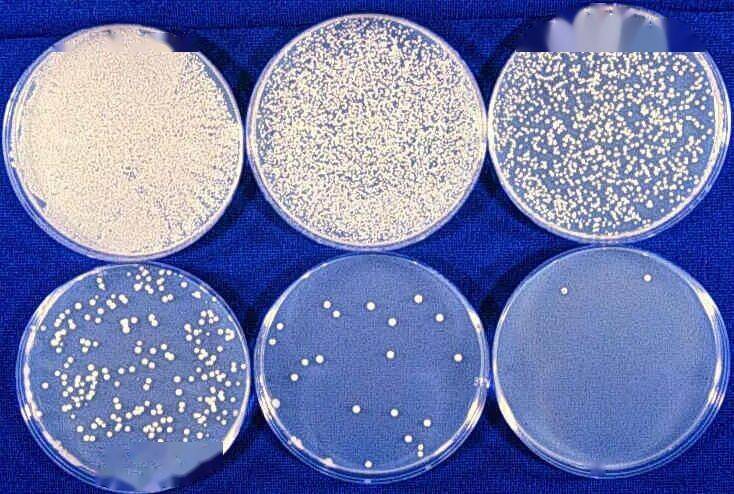
「隔夜西瓜细菌过亿,千万不能吃」,真有这么吓人吗?_菌落

蓝色的菌落

培养皿上的蓝色细菌菌落,照片
图片尺寸300x300
为什么胡萝卜营养价值高?
图片尺寸558x418
红色菌落,而大肠埃希氏菌,沙门氏菌,大肠菌群等在显色培养基上呈蓝色
图片尺寸300x300
不同颜色的菌落生长在琼脂平板上.
图片尺寸1200x795
的霉菌限制了原有葡萄球菌的生长,"葡萄球菌菌落变得透明并且被溶解"
图片尺寸900x661
图5,绿弧菌菌落图6,枯草芽孢杆菌染色微生态制剂用于改善养殖水体环境
图片尺寸1080x1126
大肠埃希氏菌蓝色菌落鼠伤寒沙门氏菌无色菌落福氏志贺氏菌无色菌落产
图片尺寸544x544
链霉菌
图片尺寸450x549
菌落总数非食品安全指标致病菌污染物危害最大
图片尺寸1000x1000
啤酒酵母的菌落 红酵母的菌落 各种酵母菌的菌落
图片尺寸1080x810
土壤样品琼脂平板上细菌和霉菌的特性及不同形态菌落背景,供微生物学
图片尺寸1200x800
「隔夜西瓜细菌过亿,千万不能吃」,真有这么吓人吗?_菌落
图片尺寸734x494
大肠杆菌的菌落
图片尺寸800x800
莫轩 的想法: #被污染的培养皿# 平凡无奇的细菌菌落,… - 知乎
图片尺寸676x677
烟曲霉的菌落
图片尺寸220x151
细菌菌落的特写
图片尺寸867x1200
mpda培养基36 ℃±1 ℃,24 h,菌落1 mm~2 mm,紫色,光滑,湿润,边缘
图片尺寸577x577
菌落检测
图片尺寸1280x960
暗室中360~366nm波长紫外灯照射下,计数平板上发浅蓝色荧光的菌落
图片尺寸1000x660
28℃,2周)接着,我们挑取少许真菌用平皿培养,2周长出了非常美丽的菌落
图片尺寸1038x1063